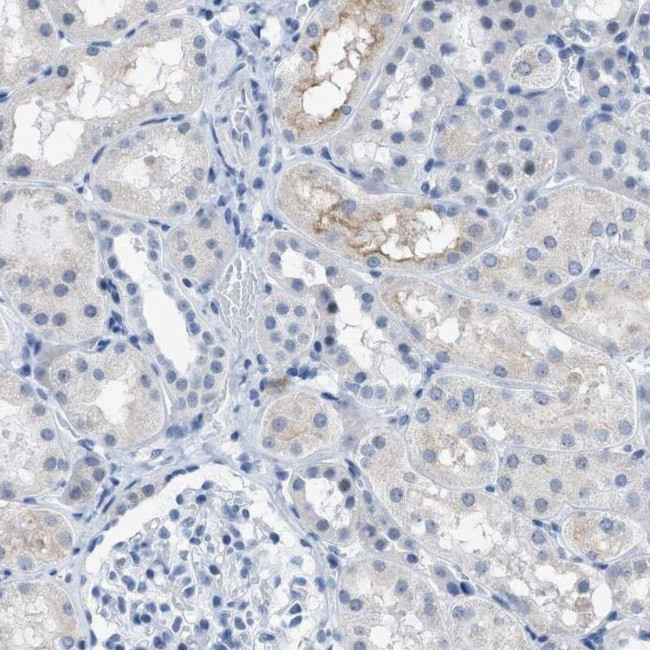
KIFC3 Antibody in Immunohistochemistry (IHC)

Search
Invitrogen
KIFC3 Polyclonal Antibody
{{$productOrderCtrl.translations['antibody.pdp.commerceCard.promotion.promotions']}}
{{$productOrderCtrl.translations['antibody.pdp.commerceCard.promotion.viewpromo']}}
{{$productOrderCtrl.translations['antibody.pdp.commerceCard.promotion.promocode']}}: {{promo.promoCode}} {{promo.promoTitle}} {{promo.promoDescription}}. {{$productOrderCtrl.translations['antibody.pdp.commerceCard.promotion.learnmore']}}
产品信息
PA5-54359
种属反应
宿主/亚型
分类
类型
抗原
偶联物
形式
浓度
规格
纯化类型
保存液
内含物
保存条件
运输条件
RRID
产品详细信息
Immunogen sequence: NIRVIARVRP VTKEDGEGPE ATNAVTFDAD DDSIIHLLHK GKPVSFELDK VFSPQASQQD VFQEVQALVT SCIDGFNVCI FAYGQT
Highest antigen sequence identity to the following orthologs: Mouse - 97%, Rat - 97%.
靶标信息
KIFC3 belongs to the large superfamily of kinesins, molecular motors that use the energy of ATP hydrolysis to translocate cargoes along microtubules. Members share extensive homology within a globular domain containing the microtubule- and ATP-binding sites and have a coiled-coil stalk domain that mediates oligomerization. Different kinesin family members participate in specific and diverse motile processes, such as cell division, organelle transport, and nuclear movement (Hoang et al., 1998 ).
仅用于科研。不用于诊断过程。未经明确授权不得转售。
篇参考文献 (0)
生物信息学
蛋白别名: DKFZp686D23201; Kinesin-like protein KIFC3; unnamed protein product
基因别名: KIFC3
UniProt ID: (Human) Q9BVG8
Entrez Gene ID: (Human) 3801